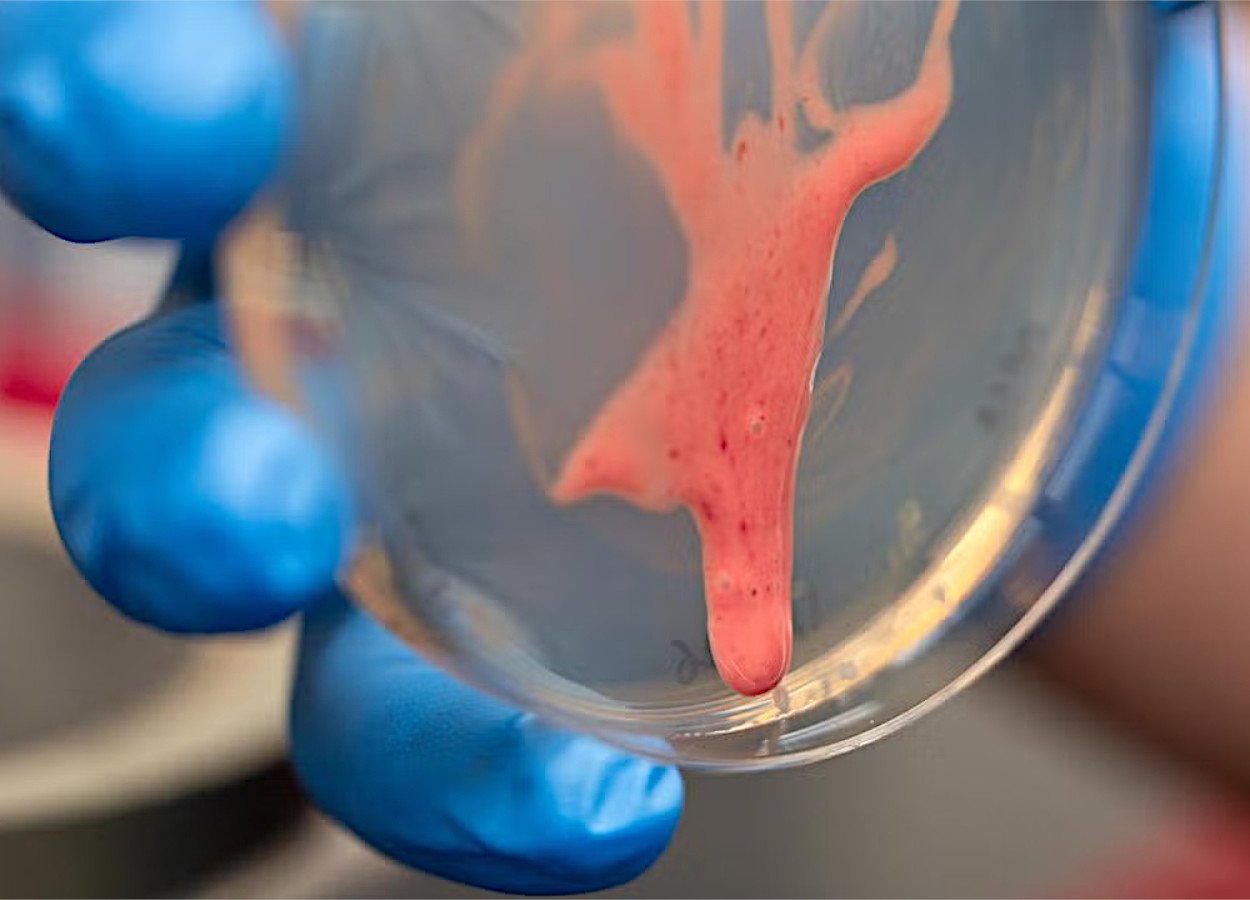
Foto:&nbsp;Jael Mackendorf, UC Davis

AgroTalk Mind estreia no Theatro Municipal de São Paulo
Evento inédito une agronegócio, Mercosul e cultura em debates sobre comércio global
Pesquisadores demonstraram que o polissacarídeo extracelular EPS-I transforma biofilmes do complexo Ralstonia solanacearum em fluidos viscoelásticos. Essa característica permite rápida disseminação da bactéria no xilema e explica a alta agressividade da murcha bacteriana em diversas culturas.
A equipe analisou o comportamento mecânico de biofilmes por reometria. Os resultados mostraram que, ao contrário de biofilmes clássicos, que se comportam como sólidos viscoelásticos, os biofilmes da bactéria apresentam dominância viscosa. Sob forças semelhantes às do fluxo de seiva, esses biofilmes afinam e passam a fluir.
O efeito depende da produção de EPS-I. Mutantes incapazes de sintetizar ou exportar esse polissacarídeo perderam a fluidez. Esses mutantes formaram biofilmes mais rígidos, com maior componente elástico, e não conseguiram se deslocar ao longo do xilema.
Ensaios em plantas confirmaram o papel do EPS-I na colonização. Em tomateiro, linhagens selvagens alcançaram maiores distâncias acima e abaixo do ponto de inoculação. Mutantes sem EPS-I mostraram menor incidência em regiões distais do caule e populações menores no local de infecção.
Experimentos em microcanais que simulam vasos do xilema reforçaram o resultado. Biofilmes com EPS-I ocuparam maior área sob taxas de fluxo intermediárias. Nessas condições, a fluidez do biofilme favoreceu a expansão coletiva da bactéria.
Testes simples em placas inclinadas evidenciaram o fenômeno. Colônias com EPS-I escorreram por ação da gravidade. Colônias sem o polissacarídeo permaneceram estáticas. Os autores chamaram esse comportamento de “mobilidade de biofilme”.
A mobilidade trouxe ganho de aptidão. Em ágar, colônias produtoras de EPS-I ocuparam maior área e concentraram até quatro vezes mais células. O custo metabólico de produzir o polissacarídeo foi compensado pelo maior acesso a água e nutrientes.
Análises genômicas indicaram que o conjunto de genes eps aparece apenas no complexo Ralstonia solanacearum. Outras espécies do gênero, isoladas de solo, água ou ambientes clínicos, não apresentaram o traço nem a mobilidade do biofilme. A origem do EPS-I coincidiu com a emergência evolutiva da murcha bacteriana.
Os pesquisadores concluem que a fluidez do biofilme representa uma inovação-chave de virulência. O EPS-I permite que a bactéria se espalhe passivamente pelos vasos, em escala de centímetros por dia. Esse mecanismo ajuda a explicar a rapidez com que plantas murcham após a infecção.
Mais informações em doi.org/10.1073/pnas.2512757123

Receba por e-mail as últimas notícias sobre agricultura